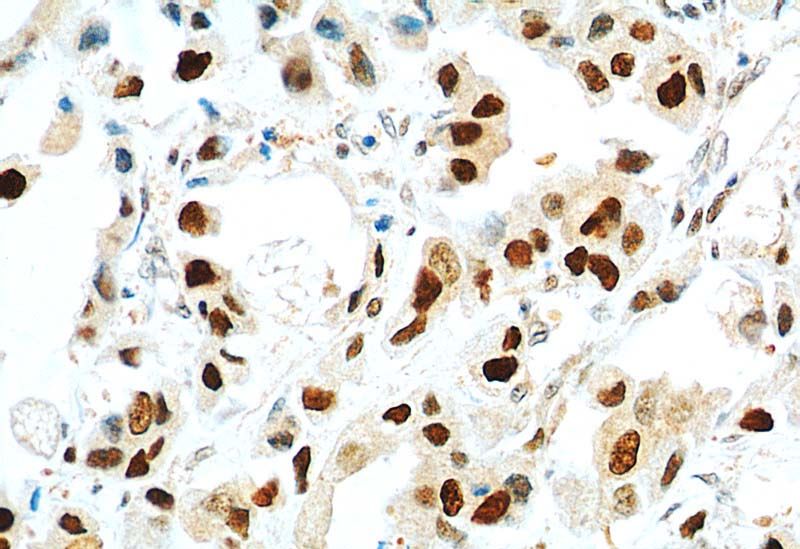
Immunohistochemical of paraffin-embedded human breast cancer using Catalog No:117335(PCNA antibody) at dilution of 1:800 (under 40x lens)

-
Product Name
PCNA antibody
- Documents
-
Description
PCNA Mouse Monoclonal antibody. Positive FC detected in MCF-7 cells. Positive IHC detected in human breast cancer tissue. Positive WB detected in HEK-293 cells, HepG2 cells. Positive IP detected in HepG2 cells. Observed molecular weight by Western-blot: 36 kDa
-
Tested applications
ELISA, IHC, FC, IP, WB
-
Species reactivity
Human, Mouse; other species not tested.
-
Alternative names
Cyclin antibody; PCNA antibody
-
Isotype
Mouse IgG1
-
Preparation
This antibody was obtained by immunization of PCNA recombinant protein (Accession Number: NM_002592). Purification method: Protein G purified.
-
Clonality
Monoclonal
-
Formulation
PBS with 0.1% sodium azide and 50% glycerol pH 7.3.
-
Storage instructions
Store at -20℃. DO NOT ALIQUOT
-
Applications
Recommended Dilution:
WB: 1:5000-1:50000
IP: 1:200-1:1000
IHC: 1:20-1:200
-
Validations
Immunohistochemical of paraffin-embedded human breast cancer using Catalog No:117335(PCNA antibody) at dilution of 1:800 (under 40x lens)

HEK-293 cells were subjected to SDS PAGE followed by western blot with Catalog No:117335(PCNA Antibody) at various dilution.

IP Result of anti-PCNA (IP:Catalog No:117335, 4ug; Detection:Catalog No:117335 1:300) with HepG2 cells lysate 3000ug.

1X10^6 MCF-7 cells were stained with 0.2ug PCNA antibody (Catalog No:117335, red) and control antibody (blue). Fixed with 90% MeOH blocked with 3% BSA (30 min). Alexa Fluor 488-congugated AffiniPure Goat Anti-Mouse IgG(H+L) with dilution 1:1500.
-
Background
Proliferating Cell Nuclear Antigen, commonly known as PCNA, is a protein that acts as a processivity factor for DNA polymerase δ in eukaryotic cells. This protein is an auxiliary protein of DNA polymerase delta and is involved in the control of eukaryotic DNA replication by increasing the polymerase's processibility during elongation of the leading strand. PCNA induces a robust stimulatory effect on the 3'-5' exonuclease and 3'-phosphodiesterase, but not apurinic-apyrimidinic (AP) endonuclease, APEX2 activities. It has to be loaded onto DNA in order to be able to stimulate APEX2. PCNA protein is highly conserved during evolution; the deduced amino acid sequences of rat and human differ by only 4 of 261 amino acids. PCNA has been used as loading control for proliferating cells.
-
References
- Wang X, Liao P, Fan X. CXXC5 Associates with Smads to Mediate TNF-α Induced Apoptosis. Current molecular medicine. 13(8):1385-96. 2013.
- Hu F, Meng X, Tong Q. BMP-6 inhibits cell proliferation by targeting microRNA-192 in breast cancer. Biochimica et biophysica acta. 1832(12):2379-90. 2013.
- Yuan SX, Tao QF, Wang J. Antisense long non-coding RNA PCNA-AS1 promotes tumor growth by regulating proliferating cell nuclear antigen in hepatocellular carcinoma. Cancer letters. 349(1):87-94. 2014.
Related Products / Services
Please note: All products are "FOR RESEARCH USE ONLY AND ARE NOT INTENDED FOR DIAGNOSTIC OR THERAPEUTIC USE"
